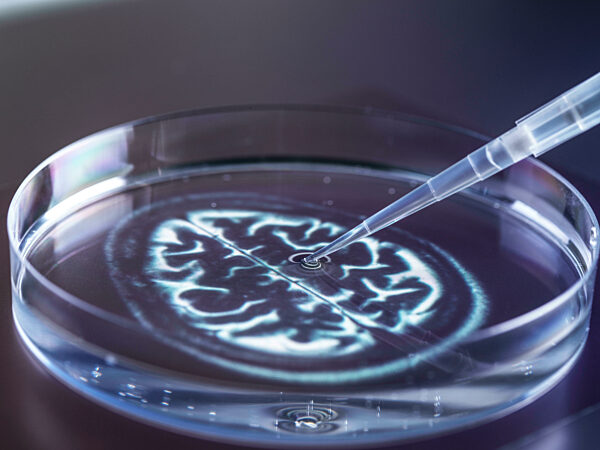
Testing of DNA in laboratory

Medizin und Forschung
Medizinischer Fortschritt kennt keinen Stillstand. Ob in der Anwendung oder im Labor - täglich werden neue Erkenntnisse gewonnen.
31.01.2025 - Pharmacist and chemical scientist doing antibiotic trials and testing in the laboratory
517718105
21.05.2025 - Eine Ärztin steht selbstbewusst in einem hellen Krankenhausflur, hält ein Krankenblatt in der Hand und lächelt mit Professionalität und Herzlichkeit
529791431
11.04.2022 - wissenschaft;labor;mikroskop;wissenschaftlerin;Bildverwendung nur mit Urhebervermerk: Monkey Business 2/Shotshop/picture alliance. Keine Exlusivverkäufe möglich.
316139801
09.12.2016 - ILLUSTRATION - Ein Arzt begruesst am 09.12.2016 in einer Arztpraxis in Hamburg eine Patientin im Sprechzimmer (gestellte Szene). Foto: Christin Klose
104574479
20.02.2024 - Freundliche Augenärztin, die in der Klinik die Augen eines Mannes mit einer Spaltlampe untersucht
454040848
02.11.2023 - Lächelnder junger Wissenschaftler, der einen Computer im Büro eines Labors benutzt
435593836
21.05.2025 - Ein weiblicher Arzt und eine Krankenschwester führen ein freundliches Gespräch, während sie in einem belebten Krankenhauskorridor medizinische Unterlagen durchsehen
529794266
26.12.2023 - Teamarbeit einer Krankenschwester und eines Arztes im Gespräch auf dem Flur eines Krankenhauses
442649302
20.09.2024 - Interaktion zwischen einem Apotheker und einer Frau an der Ladentheke, während die Frau ein Medikament kauft
487067618
02.07.2018 - Biomedical Research, female scientist viewing stem cells developing in a culture jar during an experiment in the laboratory
107595094
05.03.2019 - Health Screening, Scientist holding a tube containing a blood sample ready for analysis in the laboratory
118454472
05.01.2021 - Scientific research of nuclear transfer being carried out on several embryonic stem cells used in cloning and genetic modification
228415107
17.10.2023 - Senior scientist holding pipette and experimenting with stem cells in laboratory
431587327
25.09.2020 - team;krankenhaus;personal;Bildverwendung nur mit Urhebervermerk: Monkey Business 2/Shotshop/picture alliance. Keine Exlusivverkäufe möglich.
260443582
09.03.2024 - Das Bild zeigt einen entscheidenden Moment in der personalisierten und präventiven medizinischen Versorgung: eine medizinische Fachkraft misst den Blutdruck eines Patienten
480964675
21.05.2025 - Eine Ärztin untersucht die Lunge einer älteren Frau mit einem Stethoskop während einer medizinischen Routineuntersuchung in einer Klinik
529794080
25.10.2023 - Ärztin im Covid Genesungszentrum überprüft den Herzschlag eines älteren Patienten mit einem Stethoskop
497228132
20.09.2023 - team,krankenhaus,krankenpfleger,Bildverwendung nur mit Urhebervermerk: Monkey Business 2/Shotshop/picture alliance. Keine Exlusivverkäufe möglich.
452744080
06.02.2023 - röntgenbild,arztbesuch,patientengespräch,Bildverwendung nur mit Urhebervermerk: Monkey Business 2/Shotshop/picture alliance. Keine Exlusivverkäufe möglich.
452736544
21.05.2025 - Ärztin mit Stethoskop bei der Überprüfung von Herzschlag und Atmung eines älteren Patienten während einer medizinischen Konsultation im Krankenhaus
529795763
22.12.2024 - Elderly man receives therapeutic guidance from healthcare professional during physical rehabilitation in a medical facility. Background displays various exercises and equipment pro...
510439817
14.10.2023 - Diverse female doctors with face masks doing surgery in hospital operating room. Medicine, healthcare and medical services, unaltered.
436147231
16.12.2024 - Der Arzt hält die Hände des Patienten und bietet ihm Trost und Beruhigung während der medizinischen Beratung
502524146
20.09.2024 - Männlicher reifer Apotheker arbeitet in einem Lagerraum und sucht nach Medikamenten in einer Schublade
487068410
21.05.2025 - Eine Krankenschwester bandagiert den verletzten Knöchel eines männlichen Patienten in einem Krankenhaus und bietet Unterstützung und Pflege
529791398
02.11.2023 - Seitenansicht eines lächelnden Wissenschaftlers, der eine Blutprobe in eine Zentrifuge in einem Forschungslabor einlegt
435593434
06.11.2022 - ILLUSTRATION - Eine Sprechstundenhilfe bereitet am 06.11.2022 in Flensburg im Labor einer Praxis eine aeltere Patientin auf eine Blutabnahme vor (gestellte Szene). Foto: Benjamin N...
394549814
16.03.2025 - Rehabilitation healthcare. Physiotherapist nurse helps old man patient in wheelchair stand up walking. Man in chair for people with disability doing few steps with nurse helping. M...
520973918
30.10.2023 - manuelle therapie,osteopathie,Bildverwendung nur mit Urhebervermerk: Michelangelo Oprandi/Shotshop/picture alliance. Keine Exlusivverkäufe möglich.
452205733
10.07.2023 - röntgenbild,patientin,zahnärztin,erläutern,Bildverwendung nur mit Urhebervermerk: Addictive Stock/Shotshop/picture alliance. Keine Exlusivverkäufe möglich.
456836209
24.09.2019 - krankenbett visite krankenpfleger Bildverwendung nur mit Urhebervermerk: Monkey Business 2/Shotshop/picture alliance. Keine Exlusivverkäufe möglich.
220581398
16.05.2025 - Retired man reads medicine instructions with glasses. Age related vision loss, medication management, pharmaceutical literacy, chronic condition treatment, home healthcare, drug sa...
531489935
19.04.2021 - Male Physiotherapist explaining spine and hip model to female patient in practice
239246943
24.03.2025 - European Robotics Forum (ERF) in Stuttgart. Networking-Event für Forscher, Wissenschaftler und Unternehmen. Der Fokus in diesem Jahr liegt auf Synergien zwischen Robotik und Künstl...
517950551
Haben Sie noch nicht gefunden, was Sie suchen? Registrieren oder melden Sie sich an, um Zugriff auf eine größere Auswahl an Bildern zu erhalten und unser volles Angebot an Bildern, Videos und Grafiken zu nutzen.
Sie haben Fragen?
Haben Sie Fragen oder wünschen individuelle Beratung? Unser Team ist jederzeit für Sie da.
Verkauf / Lizenzierung
Bei Fragen rund um das Thema Lizenzierung